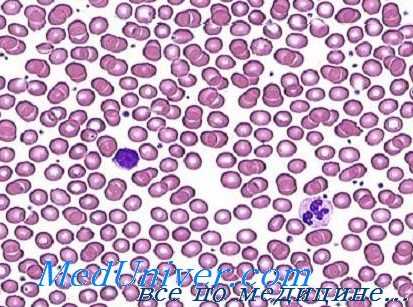
Мазок крови при железодефицитной анемии
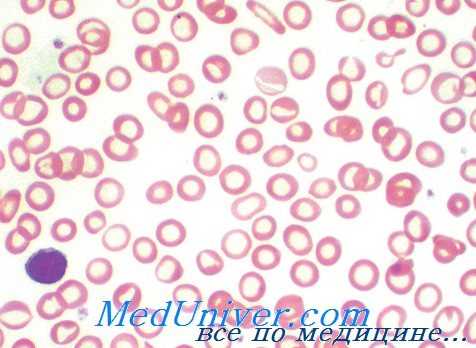
гипохромная анемия
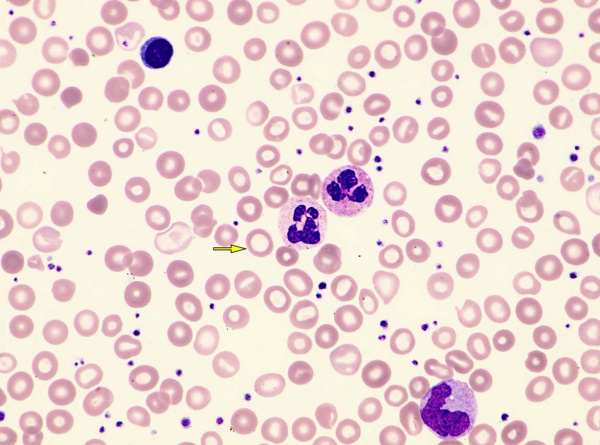
Железодефицитная анемия

Гипохромные анемии - причины, классификация
Добавил пользователь Skiper Обновлено: 08.11.2025
Лабораторная диагностика железодефицитной анемии - анализы
Периферическая кровь при железодефицитной анемии. Свойственные крови морфологические изменения заключаются в микроцитозе и гипохромии. Однако эти признаки отражают длительную недостаточность железа, сочетающуюся с тяжелой анемией. Исходно, когда в процессе гемоглобиногенеза отмечается отрицательное влияние недостаточного подвоза железа в костный мозг, кроветворение начинает приспосабливаться к новым условиям. По началу сокращается объем эритроцитов.
Микроцитоз и нормохромия обычное явление у женщин при показателе гемоглобина от 9 до 10 г на 100 мл. Гипохромия развивается, когда показатель уровня гемоглобина падает до меньших значений, причем вначале она умеренная, а затем становится все более выраженной. При тяжелой форме анемии эритроциты имеют кольчатый аспект (аннулоциты) или обретают вид клеток-мишень. Пойкилоцитоз наблюдается лишь при тяжелых формах анемии (Дачие и сотр.).
Показатели эритроцитов свидетельствуют о небольшом объеме (менее 80 мкг3), о количестве гемоглобина менее 27 пг и о средней концентрации гемоглобина на каждый эритроцит (менее 30 г/100/мл.). В принципе число ретикулоцитов в норме или немного больше; лишь е редких случаях их число занижено. Число эритроцитов обычно нормальное или немного меньшее нормы. Вот почему определение не дает точную справку о тяжести анемии. В отдельных случаях, особенно у детей, число эритроцитов превышает 5 млн/мм3. Следует отметить, что, при железодефицитной анемии увеличивается устойчивость эритроцитов к гипотонии.
Наиболее часто число лейкоцитов укладывается в норму. При длительной недостаточности железа развивается умеренная гранулоцитопения. В некоторых случаях выявляются гиперсегментированные нейтрофилы. Их появление при недостатке железа можно объяснить развитием вторичной недостаточности фолиевокислых солей или витамина В12 (Брукнер и сотр.).
В большинстве случаев показатель численности тромбоцитов высокий, однако еше не разработано четкое объяснение этому явлению. Высказана мысль о возможности появления тромбоцитоза в результате активной кровоточивости. В случаях тяжелой или длительной анемии отмечена умеренная тромбоцитопения, обратимая после проведения железотерапии.
У страдающих железодефицитной анемией количество клеточной массы в костном мозге выше нормы. Рост показателя костномозговых клеток объясняется увеличением числа эритробластов. Последние, в частности полихроматофильные и оксифильные меньших размеров, чем нормальные эритробласты в связи с сокращением количества цитоплазмы. Исследование мазка в условиях железодефицитной анемии выявляет не только малые размеры эритробластов, но также их нерегулярный, "изорванный" контур. В таких клетках были описаны аспекты дисэритропоэза и кариорексиса, почкования ядер, в некоторых случаях многоядерность и ядерные фрагменты.
Мазок крови при железодефицитной анемии
Непосредственное исследование, без окраски, размозженных на стекле зерен костного мозга не выявляет наличие аггрегатов мелких, нерегулярных, золотистых, характерных гемосидерину частиц. Окраска по Перлсу выявляет отсутствие запасного железа в макрофагах и наличие менее 10% сидеробластов (Дачие и сотр.). В целях определения заболевания железодефицитной анемией этот тест представляет наибольшее диагностическое значение.
Сывороточное железо при железодефицитной анемии. Концентрация железа в сыворотке всегда меньше 50 мкг/100 мл., причем в отдельных случаях она не больше 10 мкг/100 мл. Общая связывающая способность железа (ОССЖ), отражающая количество находящегося в кровотоке трансферина, чаще завышена и лишь в редких случаях укладывается в норму или занижена. У больных с заниженной ОССЖ возможно вмешательство и других факторов, например гипопротеинемии (McGibbon и Mollin5). Насыщение трансферином (железо сыворотки/ОССЖ х 100) в любом случае меньше 16%, однако встречаются и случаи 1%-ой насыщенности.
Следует обратить особое внимание на интерпретацию насыщения трансферином у женщин на последнем квартале беременности. У последних насыщение трансферином менее 16% не всегда указывает на наличие недостатка железа. Объяснение такому явлению следует искать в повышении количества трансферина, что характерно беременным независимо от возможного дефицита железа.
Показатель свободного протопорфирина эритроцитов (СПЭ) в принципе характеризуется высокими значениями — более 70 мкг/100 мл. а в отдельных случаях даже больше 300 мкг/мл. При этом следует обратить внимание на тот факт, что на повышение уровня СПЭ влияет больше продолжительность железо дефицита, чем его интенсивность (Dameshek).
Показатель феритина в сыворотке — растворимой формы находящегося в запасе железа—составляет менее 12 мкг/л. у женщин и детей раннего возраста и менее 35 мкг/л. у мужчин. Существует четкая взаимосвясь сывороточного феритина и количеством железа выявляемого в костном мозге и печени путем окраски по Перлсу.
Кинетика железа. В процессе выявления недостатка железа кинетика последнего не применяется как текущий метод. При использовании этого метода обнаруживается весьма быстрый клиренс железа плазмы, перенос железа в костный мозг и его расход нормальными или увеличенными эритроцитами, при этом интенсивность и скорость метаболизма железа эритроцитов больше нормы. Эти данные свидетельствуют о наличии неэффективного кроветворения в условиях недостатка железа:
Диагностирование тяжелой железодефицитной анемии по клиническим и лабораторным данным дело несложное, при этом сделанное определение подтверждается терапевтическим испытанием. Осложнения появляются при мало выраженной форме анемии и нечетких клинических и лабораторных признаках. Ниже в таблице приведены морфологические, биохимические и цитохимические данные, на основе которых дифференцируются этапы недостатка железа.

Элементы лабораторного диагноза стадий железной недостаточности
Железодефицитную анемию следует отличать от остальных видов гипохромной анемии. Среди последних, на втором месте по частоте после железодефицитной анемии, находится бета-талассемия (по данным приема для страдающих болезнями крови при Центре гематологии). Учитывая тяжесть заболевания, ранный возраст страдающего и характерную клиническую картину тяжелая бета-талассемия (анемия Кули) распознается без затруднений.
В противоположность этому легкая форма бета-талассемии в отдельных случаях не различима от железодефицитной анемии по клиническим признакам и результатам морфологического исследования крови. Возможные кровоточивость в анамнезе, наблюдаемые в слизистых оболочках и роговых образованиях изменения, равно как и бледность сыворотки подсказывают диагноз железодефицитной анемии. Гипохромия и микроцитоз общее, для обеих групп явление, однако при талассемии они выделяются более ярко.
Отмечаем, что, при талассемии, более характерной чертой микроцитоза это не сокращенный диаметр эритроцитов, а их значительно уменьшенная толщина (микроплатициты). Вот почему выраженная гипохромия с показателем гемоглобина примерно 10 г/100 мл или более подсказывает диагноз талассемии. Также, при железодефицитной анемии с более 8 г/100 мл гемоглобина пойкилоцитоз единичное явление, в то время как при талассемии наблюдается часто. В условиях талассемии выраженный микроцитоз отражается ростом численности эритроцитов, по сравнению с железодефицитной анемией.
Что касается остальных лабораторных данных следует не забывать, что при талассемии чаще наблюдаются такие признаки, как повышенное число ретикулоцитов, полихроматофильных эритроцитов и наличие точечно-базофильных красных кровяных клеток, к тому же осмотическая устойчивость последних больше.
В связи со сказанным для различения этих двух заболеваний наибольшую ценность представляют тесты метаболизма железа. В принципе, при талассемии показатель железа в крови характеризуется нормальными или завышенными значениями. Редко, у больных с хронической кровоточивостью развивается гипосидеремия. В таких случаях ОССТЖ, показатель которой при талассемии отличается низкими значениями (обычно менее 250 мкг/100 мл), увеличивается до нормы и даже более.
За исключением случаев, осложненных недостатком железа, костномозговые запасы железа при талассемии укладываются в норму или несколько больше. В отдельных случаях количество железа в митохондриях нормобластов очень велико, что создает аспект кольчатых сидеробластов.
Анемия с многонедельным течением, развивающаяся при инфекциях и хронических воспалениях, в принципе носит нормоцитный и нормохромный характер, причем эта характеристика действительна и в отношение анемий, наблюдаемых при свежих новообразованиях. Но после длительного течения в условиях этих заболеваний анемия становится микроцитной и гииохромной. В подобном случае различение этой анемии от железодефицитной возможна путем выявления первичного заболевания, в частности посредством лабораторных исследований. Морфологическое исследование крови не представляет данные, способствующие дифференциальному диагнозу.

Элементы дифференциальной диагностики при гипохромной анемии
Концентрация железа в сыворотке невелика в обеих группах заболеваний, в то время как показатель ОССТЖ в принципе высокий при железодефицитной анемии и низкий при хронических воспалениях и новообразованиях. По этой причине коэффициент насыщенности трансферина меньше у страдающих железодефицитной анемией. Обследование дополняется определением гемосидерина на костномозговом мазке. В костном мозге страдающих хроническим воспалением и новообразованием содержатся макрофаги, загруженные гемосидерином, который всегда отсутствует в условиях железодефицитной анемии. При обоих заболеваниях сидеробласты обнаруживаются в малом количестве или совсем отсутствуют.
В процессе, диагностирования возникают затруднения и в случае сидеробластической анемии. Тем не менее, в условиях сидеробластической анемии, эритроциты отличаются частным видом. На мазге различаются две популяции эритроцитов, из них одна микроцитная и гипохромная) другая — макроцитная и нормохромная («частичная гипохромия»). Дифференциальная диагностика основывается на определении метаболизма железа, который, при сидеробластической анемии, отражает нормальную или завышенную сидеремию, нормальную или низкую ОССТЖ и высокий показатель гемосидерина в костном мозге с наличием кольчатых сидеробластов.
Из гемолитических анемий наличие гипохромии отмечается при гемоглобинопатиях К, КС, Е, Кёлн. В отдельных случаях наблюдаются клетки мишень. Высокие показатели сидеремии и гемосидерина в костном мозге исключают возможность наличия железодефицитной анемии. Гемолитическая анемия с хроническим внутрисосудистым гемолизом, в частности ночной пароксизмальной гемоглобинурией сочетается с характерной для железодефицитной анемии картиной. Дифференциация возможна по признакам гемолиза и данным лабораторных анализов специфических ночной пароксизмальной гемоглобинурии.
После проведения курса лечения витамином В12 или фолиевой кислотой сидеремия и запасы железа быстро сокращаются под влиянием ускоренного эритропоэза. Это сокращение четко выражено у женщины с небольшим запасом железа. Дифференциальная диагностика представляет трудности, поскольку признаки мегалобластоза в костном мозге исчезают после проведения специфической терапии. В таком случае наиболее важным представляется исследование мазка крови, выявляющее наличие макроцитоза с нормохромией и гиперсегментирование нейтрофилов.
Нередко исследование мазка крови страдающего недостатком железа указывает на наличие нормохромии. Вот почему представляется важной постановка дифференциального диагноза по сравнению с группой нормохромных анемий. Отсутствие костномозгового гемосидерина характеризует железодефицитную анемию, даже при ее умеренной форме.
Необходимо отметить, что в условиях истинной полицитемии, эритроциты нередко гипохромные уже при первом обследовании врача, до вскрытия вен. К тому же обнаруживается невысокая сидеремия и отсутствие костномозгового запаса железа. Тем не менее истинная полицитемия отличается характерной клинической и лабораторной симптоматологией.
Редактор: Искандер Милевски. Дата обновления публикации: 18.3.2021
Гипохромные анемии - причины, классификация
К этой большой группе относятся те анемии, общей чертой которых является понимание концентрации гемоглобина в эритроцитах (до менее 34%). В принципе это нарушение сочетается с одновременным сокращением объема эритроцитов, что, морфологически, выражается микроцитозом. Следовательно, состояние эритроцитной гипохромии представляется в виде морфологической почвы развития количественно неполноценного синтезирования (сокращения) гемоглобина, составляющего основное нарушение в патогенезе гипохромной анемии.
Вместе с тем известно, что синтез гемоглобина в зритробластах предполагает одновременное образование гема (в митохондриях) и глобина (в цитоплазме). При этом синтез гема требует синтезирование протопорфирина и связывание последнего с железом. Представляется ясным, что нарушение синтезирования гемоглобина может развиться в результате расстройства синтеза протопорфирина, глобина или метаболизма железа.
Наиболее часто встречаются те гипохромные анемии, в которых происходит нарушение метаболизма железа за счет его недостатка, например при железодефицитной анемии. Реже наблюдаются гипохромные анемии, при которых железо не используется в процессе кроветворения по причине его блокирования макрофагами (анемии, развивающиеся при хронических воспалениях) или отсутствия трансферина, в связи с каким либо генетическим дефектом — например при атрансферинемии.
Нарушение синтеза протопорфирина в связи с блокированием ферментов на различных ступенях (врожденном или приобретенном) также способствует развитию гипохромной анемии, причем нередко смешанного морфологического характера (гипохромные эритроциты, сосуществующие с нормальной популяцией). Однако при этом всегда наблюдается ненормальное отложение железа в митохондриях, в виде мицелиев, способствующее образованию патологических сидеробластов, называемых кольчатыми. Вот почему эта группа анемий получила название «сидеробластических анемий».
И наконец, наиболее частое нарушение синтезирования глобина наблюдается при талассемических заболеваниях, когда замедляются темпы синтеза одной из полипептидных цепей глобина (альфа или бета).
При иных гемоглобинопатиях, таких как гемоглобин К или гемоглобин Е отмечается эритроцитная гипохромия (см. главу гемоглобинопатии).
Ниже приведена патогенетическая классификация гипохромных анемий.
Классификация гипохромных анемий
А. Нарушение в процессе синтезирования гема:
I. Нарушение метаболизма железа:
1) Анемия за счет недостатка железа
2) Анемия при хронических болезнях
3) Врожденная атрансферинемия
II. Нарушение в процессе синтезирования протопорфирина:
1) Врожденная сидеробластическая анемия (недостаточность S-аминолевулинсинтетазы и копропорфириногеноксидазы)
2) Приобретенная генуинная сидеробластическая анемия (недостаток геминсинтетазы)
3) Вторичная сидеробластическая анемия (отравление свинцом, обусловленное ГИНК, ревматоидным артритом, новообразованием и пр.).
Б. Нарушение синтеза глобина:
1) Талассемические болезни
2) Гемоглобин К, гемоглобин Е, гемоглобин "Lepore", гемоглобин "Constant Spring".
Что такое гипохромная анемия
Каждый человек, заботящийся о своем здоровье, минимум один раз в год должен исследовать состояние крови. Очень часто результаты клинического анализа, свидетельствующие об анемии, застают пациента врасплох. Поскольку часто патология никаким образом не проявляет себя, многие даже и не догадываются о развитии серьезного недуга. Одним из них является гипохромная анемия, характеризующаяся низким уровнем гемоглобина в крови. Что это такое, постараемся выяснить в данной статье.
Что представляет собой заболевание
Низкий уровень гемоглобина крови, насыщающего ткани кислородом и отвечающего за окислительно-восстановительные реакции организма, говорит о развитии малокровия. В результате анемии нарушается работа эритроцитов, внутри которых и содержится этот железосодержащий белок, приводящий к кислородному голоданию все ткани и органы.

К разновидности малокровия относится гипохромная анемия, или гипохромия.
Давайте подробно рассмотрим, что такое гипохромия. Это общее наименование всех форм малокровия, развивающегося на фоне снижения концентрации гемоглобина в эритроцитах, сопровождаемого уменьшением цветового значения ниже 0,8 г/л. Красные кровяные тельца меняют не только цвет, но диаметр (микроцитоз/макроцитоз) и форму (пойкилоцитоз).
При гипохромии они приобретают вид кольца с бледно-красноватой серединой и темно-красным окаймлением.
Анемия гипохромная имеет несколько форм проявления. Попытаемся объяснить, что такое виды гипохромной анемии. В медицине диагностируется:
- Железодефицитная анемия, возникающая в результате значительной кровопотери, плохого усвоения железа, на фоне вынашивания плода. Характеризуется снижением железа в сыворотке крови, изменением цвета эритроцитов. Различают нормоцитарную, микроцитарную и макроцитарную анемии, основополагающим фактором этих видов гипохромии является дефицит железа. Излечение гипохромии наступает после приема железосодержащих препаратов.
- Перераспределительная анемия распознается по избыточной концентрации железа и эритроцитному гемолизу, возникающим на фоне протекающих в организме гнойных и воспалительных процессов. Клинические исследования фиксируют нормальное содержание железа, низкий гемоглобин, гипохромию, изменение эритроцитов. Лечение железосодержащими лекарствами данного вида гипохромной анемии не приносит эффекта.
- Сидероахрестическая, или железонасыщенная анемия — недостаточное всасывание железа, приводящее к снижению гемоглобина и изменению цвета красных кровяных клеток. Развивается на фоне интоксикации организма и других патологий, характеризующихся нарушением абсорбции питательных веществ в кишечнике. Терапия этой гипохромии железосодержащими лекарствами безрезультатна.
- Смешанная анемия включает различные признаки гипохромных анемий, сопровождаемых малым значением гемоглобина в красных кровяных клетках и изменением их цвета.
Выше указанные гипохромные анемии, даже слабо выраженные, несут опасность здоровью человека. У новорожденных детей гипохромия часто становится причиной отставания в развитии. У беременных анемия становится причиной плохого развития плода и чаще всего выражается малым веса плода. Гипохромия у взрослых ухудшает качество жизни, приводит к сбою в работе жизненно важных органов и систем, угрожая развитием разных заболеваний, в том числе смертельно опасных.
Почему возникает гипохромия
В медицине выделяют три основных причины развития гипохромии, зависящие от вида анемии:
- Обильные потери железа в результате кровотечений или чересчур интенсивный расход полезного элемента ведет к развитию железодефицитной анемии.
- Нарушение процесса всасывания железа в кишечнике, вследствие чего железо, попадающее с пищей, выводится из организма. В этом случае развивается сидероахрестический или смешанный типы. Часто такая гипохромия развивается на фоне медикаментозного лечения некоторыми препаратами.
- Малое попадание железа через продукты питания является источником анемии смешанного типа.
Чаще всего гипохромию провоцируют следующие факторы:
- несбалансированное питание, потребление пищи, практически не содержащей витаминов, железа, дефицит животного белка в рационе, авитаминоз;
- постоянные или периодически возникающие кровотечения (носовые, кишечные, желудочные), маточные кровотечения, длительные обильные менструации, кровоточивость десен;
- острая массивная кровопотеря;
- желудочно-кишечные патологии, препятствующие усвоению железа (энтериты, гельминтозы, острые/хронические инфекции, гастриты, дисбактериозы, болезнь Крона, нарушение абсорбции кишечника);
- отравление вредными токсическими веществами;
- оперативные вмешательства;
- вынашивание ребенка и грудное вскармливание;
- злокачественные заболевания крови и другие раковые новообразования;
- частые стрессовые ситуации, имеющие затяжной характер;
- хронические инфекционные болезни (туберкулез, воспаление легких, патологии печени/почек).
Кроме этого диагностируют гипохромную анемию по причине наличия у пациента аутоиммунных заболеваний (волчанка, васкулит, гломерулонефрит, ревматоидный артрит и др.), формирующих иммунные комплексы, содержащие эритроциты и в то же время вырабатывающие антитела против собственных красных кровяных телец.
Как проявляется гипохромия
Особенностью гипохромии является длительное бессимптомное течение. Заболевший зачастую не догадывается о наличии гипохромной анемии, списывая плохое самочувствие на частые стрессы и чрезмерные нагрузки.
Пациенты часто жалуются на общее недомогание, мышечную слабость, снижение выносливости, быструю утомляемость (особенно после физического труда), постоянное чувство сонливости. По мере осложнения течения гипохромной анемии симптомы увеличиваются.
В таблице представлены симптомы гипохромии в зависимости от степени тяжести:
нарушение частоты и глубины дыхания, чувство нехватки воздуха;
гипотония;
болезненное покраснение языка;
изменение вкусовых пристрастий.
Чтобы избежать тяжелых осложнений, важно своевременно диагностировать и лечить гипохромную анемию, иначе последствия патологии могут быть разными, вплоть до угрозы жизни.
Способы диагностики заболевания
Распознать гипохромную анемию можно только путем лабораторного исследования крови. Для этого пациенту достаточно сдать клинический анализ крови, выявляющий содержание гемоглобина, число эритроцитов и их цветовой показатель.
В таблице представлена расшифровка нормальных и патологических показателей гемоглобина:
| Категория пациентов | Норма гемоглобина (грамм/литр) | Патология гемоглобина (грамм/литр) |
|---|---|---|
| Мужчины | от 130 до 160 | ниже 130 |
| Женщины | от 120 до 150 | ниже 120 |
| Беременные | от 110 до 150 | ниже 110 |
| Дети до 5 лет | 110 | ниже 110 |
| У детей первого месяца жизни | ||
| от 130 до 120 | ниже 130-120 | |
| Нормальное значение железосодержащего белка животных в эритроцитах составляет 0,85–1,15. Цветовые показатели ниже 0,8 говорят о наличии гипохромии. | ||
При необходимости для выявления гипохромной анемии дополнительно измеряют:
- средний размер и объем красных кровяных клеток, число ретикулоцитов;
- реагирование на железосодержащие препараты (проба с Десфералем);
- биохимия крови;
- наличие скрытой крови в кале.
По результатам лабораторных исследований при гипохромии могут дополнительно назначить аппаратную диагностику и другие анализы:
- ФГС/ФГДС;
- колоноскопия;
- рентген грудной клетки;
- УЗИ брюшной полости, почек;
- осмотр гинеколога (женщинам).
- анализ мочи.
В любом случае самолечением при гипохромии заниматься нельзя, несмотря на то что каждому пациенту доступна сдача любого анализа в платной лаборатории. При первых признаках гипохромии следует срочно идти на прием к врачу. Специалист проведёт визуальный осмотр, изучит анамнез. Подтвердить диагноз «гипохромная анемия» и установить истинную причину болезни можно только при проведении лабораторного исследования крови.
Как лечить недуг
Гипохромная анемия без лечения приводит к общей гипоксии всех внутренних органов и тканей. Восстановить состояние организма при гипохромии очень сложно. Поэтому лечение гипохромной анемии важно начать с самой ранней стадии заболевания, это обеспечит более высокий терапевтический эффект.
План и вид лечения гипохромии назначается врачом и зависит от формы патологии:
- При железодефицитной анемии назначают железосодержащие лекарства: ферронал, гемофер, фенюльс, актиферрин — с целью восполнения железа и восстановления синтеза гемоглобина. Принимать их нужно в соответствии с врачебными рекомендациями в одно и то же время. Грамотно составленное меню с преобладанием белковой и железосодержащей пищи станет отличным дополнением к лекарственной терапии при гипохромии.
- При сидероахрестической анемии сначала необходимо устранить основное заболевание, провоцирующее нарушение всасывания железа, а затем восстанавливать уровень гемоглобина. В этом случае начинают с употребления витаминных комплексов (лучше В12). После курса витаминотерапии при анемии назначают железосодержащие препараты. Для контроля гипохромии требуется постоянный забор крови на наличие свободного железа.
- Смешанная гипохромная анемия, при лечении которой используют указанные выше методы, требует проведения полного обследования организма на возможное развитие злокачественных опухолей. Если опухоль обнаружена, назначают цитостатические лекарственные средства или используют радикальные методы лечения гипохромии вплоть до оперативного вмешательства.
Медикаментозные препараты, рекомендованные к употреблению при гипохромии, выпускаются в виде суспензии, капсул или таблеток.
Внутримышечные/внутривенные инъекции при анемии назначают только при сопутствующих болезнях желудочно-кишечного тракта и обильных/острых кровотечениях.
Средняя и тяжелая степени гипохромной анемии лечатся под наблюдением врача в условиях стационара.
В качестве поддержки к основному лечению гипохромии прибегают к народным методам лечения. Чтобы повысить уровень гемоглобина, при гипохромии рекомендуется каждый день кушать:
- тертую сырую морковь, приправленную сметаной;
- вареную тыкву;
- отвар шиповника/крапивы;
- смеси сушеных фруктов с медом.
Не стоит забывать и о правильном питании больных гипохромией. Диетологи дают следующие рекомендации:
- Ежедневно потреблять 130-150 г белковой пищи (мясо крупнорогатого скота).
- Сведите к минимуму употребление жиров. Малокровие способствует ожирению костного мозга/печени, угнетающего процесс кроветворения.
- Для улучшения аппетита включите разные бульоны.
- Употребление сырья, богатого витамином В (яйца, рыба, творог, пивные дрожжи, печень).
Можно лечить гипохромию разными способами, главное одно — начинать на ранней стадии, не допуская осложнений.
Обычно гипохромия лечится около 2-3 месяцев.
При тяжелой стадии гипохромной анемии терапия может затянуться надолго.
Помните слова Сократа: «Здоровье не всё, но всё без здоровья ничто». Поэтому не забывайте своевременно устранять воспаления и инфекции, сбалансированно питайтесь, пейте витаминные комплексы, обследуйте организм и сдавайте кровь на анализ. Это позволит вовремя выявить гипохромию и избавит от серьезных проблем.
Железодефицитная анемия ( Гипохромная анемия , Микроцитарная анемия )
Железодефицитная анемия – синдром, обусловленный недостаточностью железа и приводящий к нарушению гемоглобинопоэза и тканевой гипоксии. Клинические проявления представлены общей слабостью, сонливостью, пониженной умственной работоспособностью и физической выносливостью, шумом в ушах, головокружениями, обморочными состояниями, одышкой при нагрузке, сердцебиением, бледностью. Гипохромная анемия подтверждается лабораторными данными: исследованием клинического анализа крови, показателей сывороточного железа, ОЖСС и ферритина. Терапия включает лечебную диету, прием препаратов железа, в некоторых случаях – трансфузию эритроцитарной массы.
МКБ-10




Общие сведения
Железодефицитная (микроцитарная, гипохромная) анемия – анемия, обусловленная нехваткой железа, необходимого для нормального синтеза гемоглобина. Её распространенность в популяции зависит от половозрастных и климатогеографических факторов. По обобщенным сведениям, гипохромной анемией страдает около 50% детей раннего возраста, 15% женщин репродуктивного возраста и около 2% мужчин. Скрытый тканевой железодефицит выявляется практически у каждого третьего жителя планеты. На долю микроцитарной анемии в гематологии приходится 80–90% всех анемий. Поскольку железодефицит может развиваться при самых различных патологических состояниях, данная проблема актуальна для многих клинических дисциплин: педиатрии, гинекологии, гастроэнтерологии и др.
Причины
Ежесуточно с потом, калом, мочой, слущенными клетками кожи теряется около 1 мг железа и примерно столько же (2-2,5 мг) поступает в организм с пищей. Дисбаланс между потребностями организма в железе и его поступлением извне или потерями способствует развитию железодефицитной анемии. Железодефицит может возникать как при физиологических условиях, так и в результате ряда патологических состояний и быть обусловлен как эндогенными механизмами, так и внешними воздействиями:
Кровопотери
Чаще всего анемия вызывается хронической потерей крови: обильными менструациями, дисфункциональными маточными кровотечениями; желудочно-кишечными кровотечениями из эрозий слизистой желудка и кишечника, гастродуоденальных язв, геморроидальных узлов, анальных трещин и др. Скрытая, но регулярная кровопотеря отмечается при гельминтозах, гемосидерозе легких, экссудативном диатезе у детей и др.
Особую группу составляют лица с болезнями крови - геморрагическими диатезами (гемофилией, болезнью Виллебранда), гемоглобинурией. Возможно развитие постгеморрагической анемии, вызванной одномоментным, но массивным кровотечением при травмах и операциях. Гипохромная анемия может возникать вследствие ятрогенных причин - у доноров, часто сдающих кровь; пациентов с ХПН, находящихся на гемодиализе.
Нарушение поступления, всасывания и транспорта железа
К факторам алиментарного порядка относятся анорексия, вегетарианство и следование диетам с ограничением мясных продуктов, плохое питание; у детей - искусственное вскармливание, позднее введение прикорма. Снижение абсорбции железа характерно для кишечных инфекций, гипоацидного гастрита, хронического энтерита, синдрома мальабсорбции, состояния после резекции желудка или тонкой кишки, гастрэктомии. Значительно реже железодефицитная анемия развивается вследствие нарушения транспортировки железа из депо при недостаточной белково-синтетической функции печени – гипотрансферринемиях и гипопротеинемиях (гепатитах, циррозе печени).
Повышенное расходование железа
Ежедневная потребность в микроэлементе зависит от пола и возраста. Наиболее высока необходимость в железе у недоношенных, детей раннего возраста и подростков (в связи с высокими темпами развития и роста), женщин репродуктивного периода (в связи с ежемесячными менструальными потерями), беременных (в связи с формированием и ростом плода), кормящих мам (в связи с расходом в составе молока). Именно эти категории являются наиболее уязвимыми в отношении развития железодефицитной анемии. Кроме того, повышение потребности и расхода железа в организме наблюдается при инфекционных и опухолевых заболеваниях.
Патогенез
По своей роли в обеспечении нормального функционирования всех биологических систем железо является важнейшим элементом. От уровня железа зависит поступление кислорода к клеткам, протекание окислительно-восстановительных процессов, антиоксидантная защита, функционирование иммунной и нервной систем и пр. В среднем содержание железа в организме находится на уровне 3-4 г. Более 60% железа (>2 г) входит в состав гемоглобина, 9% - в состав миоглобина, 1% - в состав ферментов (гемовых и негемовых). Остальное железо в виде ферритина и гемосидерина находится в тканевом депо – главным образом, в печени, мышцах, костном мозге, селезенке, почках, легких, сердце. Примерно 30 мг железа непрерывно циркулирует в плазме, будучи частично связанным основным железосвязывающим белком плазмы – трансферрином.
При развитии отрицательного баланса железа мобилизуются и расходуются запасы микроэлемента, содержащиеся в тканевых депо. На первых порах этого бывает достаточно для поддержания адекватного уровня Hb, Ht, сывороточного железа. По мере истощения тканевых резервов компенсаторно увеличивается эритроидная активность костного мозга. При полном истощении эндогенного тканевого железа его концентрация начинает снижаться в крови, нарушается морфология эритроцитов, уменьшается синтез гема в гемоглобине и железосодержащих ферментов. Страдает кислородтранспортная функция крови, что сопровождается тканевой гипоксией и дистрофическими процессами во внутренних органах (атрофический гастрит, миокардиодистрофия и др.).
Классификация
Железодефицитная анемия возникает не сразу. Вначале развивается предлатентный железодефицит, характеризующийся истощением только запасов депонированного железа при сохранности транспортного и гемоглобинового пула. На этапе латентного дефицита отмечается уменьшение транспортного железа, содержащегося в плазме крови. Собственно гипохромная анемия развивается при уменьшении всех уровней метаболических запасов железа – депонированного, транспортного и эритроцитарного. В соответствии с этиологией различают анемии: постгеморрагические, алиментарные, связанные с повышенным расходом, исходным дефицитом, недостаточностью резорбции и нарушением транспорта железа. По степени выраженности железодефицитные анемии подразделяются на:
- Легкие (Нb 120-90 г/л). Протекают без клинических проявлений или с их минимальной выраженностью.
- Среднетяжелые (Нb 90-70 г/л). Сопровождаются циркуляторно-гипоксическим, сидеропеническим, гематологическим синдромами умеренной степени выраженности.
- Тяжелые (Нb
Симптомы
Циркуляторно-гипоксический синдром обусловлен нарушением синтеза гемоглобина, транспорта кислорода и развитием гипоксии в тканях. Это находит свое выражение в ощущении постоянной слабости, повышенной утомляемости, сонливости. Пациентов преследует шум в ушах, мелькание «мушек» перед глазами, головокружения, переходящие в обмороки. Характерны жалобы на сердцебиение, одышку, возникающую при физической нагрузке, повышенную чувствительность к низким температурам. Циркуляторно-гипоксические нарушения могут усугублять течение сопутствующей ИБС, хронической сердечной недостаточности.
Развитие сидеропенического синдрома связано с недостаточностью тканевых железосодержащих ферментов (каталазы, пероксидазы, цитохромов и др.). Этим объясняется возникновение трофических изменений кожных покровов и слизистых оболочек. Чаще всего они проявляются сухостью кожи; исчерченностью, ломкостью и деформацией ногтей; повышенным выпадением волос. Со стороны слизистых оболочек типичны атрофические изменения, что сопровождается явлениями глоссита, ангулярного стоматита, дисфагии, атрофического гастрита. Может возникать пристрастие к резким запахам (бензина, ацетона), искажение вкуса (желание есть глину, мел, зубной порошок и пр.). Признаками сидеропении также служат парестезии, мышечная слабость, диспепсические и дизурические расстройства. Астеновегетативные нарушения проявляются раздражительностью, эмоциональной неустойчивостью, снижением умственной работоспособности и памяти.

Осложнения
Поскольку в условиях железодефицита IgA теряет свою активность, больные становятся подвержены частой заболеваемости ОРВИ, кишечными инфекциями. Пациентов преследует хроническая усталость, упадок сил, снижение памяти и концентрации внимания. Длительное течение железодефицитной анемии может привести к развитию миокардиодистрофии, распознаваемой по инверсии зубцов Т на ЭКГ. При крайне тяжелом железодефиците развивается анемическая прекома (сонливость, одышка, резкая бледность кожи с цианотичным оттенком, тахикардия, галлюцинации), а затем – кома с потерей сознания и отсутствием рефлексов. При массивной стремительной кровопотере возникает гиповолемический шок.
Диагностика
На наличие железодефицитной анемии может указывать внешний вид больного: бледная, с алебастровым оттенком кожа, пастозность лица, голеней и стоп, отечные «мешки» под глазами. При аускультации сердца обнаруживается тахикардия, глухость тонов, негромкий систолический шум, иногда – аритмия. С целью подтверждения анемии и определения ее причин проводится лабораторное обследование.
- Лабораторные тесты. В пользу железодефицитного характера анемии свидетельствует снижение гемоглобина, гипохромия, микро- и пойкилоцитоз в общем анализе крови. При оценке биохимических показателей отмечается снижение уровня сывороточного железа и концентрации ферритина (60 мкмоль/л), уменьшение насыщения трансферрина железом (
- Инструментальные методики. Для установления причины хронической кровопотери должно быть проведено эндоскопическое обследование ЖКТ (ЭГДС, колоноскопия,), рентгенодиагностика (ирригоскопия, рентгенография желудка). Обследование органов репродуктивной системы у женщин включает УЗИ малого таза, осмотр на кресле, по показаниям - гистероскопию с РДВ.
- Исследование пунктата костного мозга. Микроскопия мазка (миелограмма) показывает значительное снижение количества сидеробластов, характерное для гипохромной анемии. Дифференциальная диагностика направлена на исключение других видов железодефицитных состояний - сидеробластной анемии, талассемии.

Лечение
К основным принципам терапии железодефицитной анемии относятся устранение этиологических факторов, коррекция рациона питания, восполнение железодефицита в организме. Этиотропное лечение назначается и проводится специалистами гастроэнтерологами, гинекологами, проктологами и др.; патогенетическое – гематологами. При железодефицитных состояниях показано полноценное питание с обязательным включением в рацион продуктов, содержащих гемовое железо (телятины, говядины, баранины, мяса кролика, печени, языка). Следует помнить, что усилению ферросорбции в ЖКТ способствуют аскорбиновая, лимонная, янтарная кислота. Ингибируют всасывание железа оксалаты и полифенолы (кофе, чай, соевый протеин, молоко, шоколад), кальций, пищевые волокна и др. вещества.
Вместе с тем, даже сбалансированная диета не в состоянии устранить уже развившийся недостаток железа, поэтому больным с гипохромной анемией показана заместительная терапия ферропрепаратами. Препараты железа назначаются курсом не менее 1,5-2-х месяцев, а после нормализации уровня Hb проводится поддерживающая терапия в течение 4-6 недель половинной дозой препарата. Для фармакологической коррекции анемии используются препараты двухвалентного и трехвалентного железа. При наличии витальных показаний прибегают к гемотрансфузионной терапии.

Прогноз и профилактика
В большинстве случаев гипохромная анемия подается успешной коррекции. Однако при неустраненной причине железодефицит может рецидивировать и прогрессировать. Железодефицитная анемия у детей раннего и младшего возраста может вызывать задержку психомоторного и интеллектуального развития (ЗПР). В целях профилактики железодефицита необходим ежегодный контроль параметров клинического анализа крови, полноценное питание с достаточным содержанием железа, своевременная ликвидация источников кровопотери в организме. Следует учитывать, что лучше всего усваивается железо, содержащееся в мясе и печени в форме гема; негемовое железо из растительной пищи практически не усваивается – в этом случае оно сначала должно восстановиться до гемового при участии аскорбиновой кислоты. Лицам групп риска может быть показан профилактический прием железосодержащих препаратов по назначению специалиста.
3. Федеральные клинические рекомендации по диагностике и лечению железодефицитных анемий/ Румянцев А.Г. и соавт. - 2015.
4. Железодефицитная анемия у женщин молодого возраста: аспекты качества жизни и оптимизация лечения: Автореферат диссертации/ Абдуллина Л.Р. - 2007.
Нормохромная анемия: понятие, формы и причины, критерии и диагностика, лечение
Одним из важнейших условий для нормального функционирования всех клеток организма является достаточное обеспечение их источниками энергии. Самым важным процессом при этом является клеточное дыхание, осуществляемое на молекулярном уровне. Это жизненно необходимые процессы окисления кислорода с высвобождением при таких химических реакциях молекул, дающих клетке энергетический потенциал для дальнейшей жизнедеятельности. Субстратами для таких процессов являются кислород и глюкоза. И то, и другое приносится к каждой клетке организма форменными элементами крови, в частности, эритроцитами. Эритроциты содержат в своем составе гемоглобин – вещество, способное принять молекулу кислорода и отдать ее клетке с заменой на молекулу углекислого газа.

Именно снижение гемоглобина в периферической крови и называется анемией, или малокровием.
Норма и патология

Здесь следует упомянуть не только о нормальных показателях содержания гемоглобина в крови (120-130 г/л), но еще и о том, как вообще красные клетки крови появляются в нашем организме. Основным источником гемопоэза, или кроветворения, является некая клетка-предшественница, способная дать начало всем росткам красной (эритроциты) и белой (лейкоциты, тромбоциты) крови. Из этой стволовой клетки образуются предшественники эритроцитов, которые после нескольких этапов дифференцировки трансформируются в ретикулоциты (незрелые эритроциты, сохраняющие внутри остатки клеточного ядра), а далее в эритроциты без клеточных ядер.
Эритроциты способны осуществлять свою жизнедеятельность на протяжении 3-4-х месяцев, после чего при прохождении крови через селезенку, захватываются её макрофагами и перевариваются. Селезенку также называют «кладбищем эритроцитов».
При снижении количества эритроцитов в периферической крови причинный, пусковый фактор может оказывать влияние на любом этапе дифференцировки клеточных элементов. Вот почему врачу важно знать, что конкретно могло спровоцировать возникновение анемии.
Какие виды анемий бывают?
Итак, анемией считается клинико-гематологический синдром, сопровождающийся снижением уровня гемоглобина в периферической крови менее 120 г/л для лиц женского пола и менее 130 г/л для лиц мужского пола.
Анемии различаются по содержанию гемоглобина в самих эритроцитах (гипохромная, нормохромная и гиперхромная анемии, соответственно, с низким, с нормальным, или с повышенным содержанием гемоглобина в эритроцитах):

а также по размеру эритроцитов (микрохромная, нормохромная и макроцитарная, соответственно, с маленьким, с нормальным или с большим размером).

Нормохромной нормоцитарной анемией, которую рассмотрим в данном материале, называется снижение гемоглобина в крови, характеризующееся нормальным содержанием гемоглобина в эритроците и нормальным размером эритроцитов. То есть – снижением именно числа эритроцитов.
Соответственно, в связи с тем, что эритроцитов в крови меньше, чем обычно, и уровень общего гемоглобина также снижается. Тем не менее, цветовой показатель остается нормальным (0.85-1.1).
Почему развивается нормохромная анемия?

Такой вид анемии является полиэтиологичным, то есть существует много причин, способных привести к снижению уровня эритроцитов и гемоглобина. Основные причины следующие:
- Гемолиз. Это состояние, сопровождающееся повышенным разрушением эритроцитов вследствие механического, токсического, инфекционного или аутоиммунного воздействия на их клеточные мембраны. В периферической крови происходит массивный лизис эритроцитов со снижением количества гемоглобина, в результате чего страдает транспортная функция крови. К таким агентам относятся вирусные и бактериальные инфекции (грипп, коклюш, тиф, паратиф, корь и др), отравления токсинами, ядами, тяжелыми металлами, а также некоторые системные аутоиммунные заболевания (системная красная волчанка, ревматоидный артрит и др).
- Апластический синдром. Это тяжелый клинико-гематологический синдром, возникающий в результате: поражения организма солями тяжелых металлов, ионизирующим излучением, лекарственными препаратами. Характеризуется не только нормоцитарной анемией вследствие угнетения образования эритроцитов, но и угнетением всех трех ростков кроветворения (лейкоциты, тромбоциты, эритроциты). Это называется панцитопенией.
- Заболевания мочевыделительной системы. Здесь имеются ввиду не столько воспалительные заболевания нижних мочевых путей, сколько тяжелые, хронические болезни почек, особенно с развитием хронической почечной недостаточности. В веществе почек вырабатывается фактор, влияющий на гемопоэз, в частности, на образование новых эритроцитов. Этот фактор называется эритропоэтином. При хронических заболеваниях (хронический гломерулонефрит, диабетическая нефропатия с исходом в нефросклероз) значительная часть почечной ткани замещается рубцовой, в связи с чем эритропоэтин вырабатываться не может. Особенно тяжелые анемии наблюдаются у пациентов на гемодиализе, получающих заместительную почечную терапию посредством аппарата искусственной почки.
- Геморрагический синдром. Нормохромная нормоцитарная анемия чаще всего развивается при кровопотерях. Это могут быть любые кровотечения – как вследствие наружных механических повреждений, так и внутренних кровотечений. Из поражений внутренних органов особое значение имеют желудочно-кишечные кровотечения при язве желудка, синдроме Мэллори-Вэйса и при циррозах печени, а также маточные кровотечения у женщин в период менопаузы. Часто развитию анемии способствуют врожденные и приобретенные нарушения свертывающей системы крови (гемофилия, болезнь Верльгофа и др).
- Злокачественные новообразования. На развитие нормохромной анемии могут повлиять злокачественные опухоли кроветворной системы (Ходжкинская и неходжкинская лимфомы, лейкозы), а также опухоли, локализующиеся в любом другом органе. Особенно часто к развитию тяжелой нормохромной анемии приводит рак желудка. Патогенез развития анемии здесь сводится к тому, что опухоль выделяет токсины в кровь, которые и провоцируют угнетение кроветворения и повышенное разрушение эритроцитов в периферической крови.
- Воспалительные заболевания. Такое понятие, как анемия хронического воспаления обусловлена, обусловлено воздействием на клеточную стенку эритроцитов провоспалительных белков (цитокинов), длительно циркулирующих в крови. Именно поэтому часть эритроцитов постепенно разрушается, а кроме этого, значительно уменьшается их продолжительность жизни. Также провоспалительные белки опосредованно влияют на обмен гемоглобина, что также приводит к снижению его содержания в организме.
Как проявляется нормохромная анемия?
Для данной патологии характерен типичный клинико-гематологический синдром – это не только изменения в анализе периферической крови, но и определенная симптоматика. В первую очередь, пациенты отмечают сильно выраженную слабость и повышенную утомляемость. Зачастую появляются головокружение, мелькание мушек перед глазами, некоторая оглушенность. Могут быть потери сознания, особенно при резком вставании – так называемая ортостатическая гипотензия. При анемии средней и тяжелой степени появляется одышка, обусловленная общей гипоксией организма.

Многие пациенты отмечают тусклость и ломкость волос и ногтей.
При осмотре врач отмечает бледность кожного покрова и видимых слизистых оболочек, голубоватую окраску склер, учащенный пульс вследствие компенсаторной работы сердечной мышцы с целью увеличения перекачиваемой крови в минуту и, таким образом, снабжения тканей организма оксигенированной кровью.
Тяжелые заболевания, спровоцировавшие возникновение нормохромной анемии, имеют соответствующую симптоматику:
- при гемолизе – желтушность кожного покрова и склер, могут быть боли в подреберьях, повышается температура тела,
- при злокачественных опухолях очень актуален «синдром малых признаков» – бледность, значительное похудание, отсутствие аппетита, отвращение к мясной пище, субфебрильная лихорадка,
- при хронической почечной недостаточности – отеки, одышка, диспепсические явления вследствие «зашлакованности» организма мочевиной и креатинином, уменьшение или отсутствие мочеиспускания,
- при хронических воспалительных заболеваниях – признаки поражения соответствующих систем организма.
Диагностика нормохромной нормоцитарной анемии
Кроме клинического осмотра и сбора анамнеза, врач в обязательном порядке назначает общий анализ крови. Обязательным критерием диагностики при этом является снижение гемоглобина (менее 130 г/л для лиц мужского пола и менее 120 г/л для лиц женского пола) и снижение эритроцитов (3,8 млн/мкл).

При необходимости, с целью дифференциальной диагностики нормохромной анемии от других форм могут быть назначено определение таких биохимических и иммунохимических показателей, как:
- Железо сыворотки крови (норма – Мужчины: 12,5 – 32,2 мкмоль/л Женщины: 10,7 – 32,2 мкмоль/л), показатель, отражающий латентный (скрытый) дефицит железа при нормальном содержании гемоглобина в крови, но при наличии всех клинических проявлений анемии.
- Общая железосвязывающая способность сыворотки крови (норма ОЖСС – 27,8 – 53,7 мкмоль/л). Повышается при дефиците железа, понижается при нормохромной и гиперхромной анемиях.
- Трансферрин – это белок, циркулирующий в крови, основной функцией которого является транспорт железа от эритроцитов к клеткам всех внутренних органов (норма 2,0 – 3,6 г/л). При железодефицитной анемии содержание его повышается, потому что возрастает количество «свободного», незадействованного белка, а при гемолитической анемии количество его наоборот, понижается, потому что слишком много железа поступает в периферическую кровь, и все атомы железа связаны трансферрином, то есть свободного белка очень мало.
- Ферритин – это белок, основной функцией которого является депонирование атомов железа, в норме содержится в печени, селезенке, мышцах (норма – Мужчины: 20 – 250 мкг/л Женщины: 10 – 120 мкг/л), при железодефицитной анемии содержание его в крови снижается, а при нормохромной анемии – наоборот, возрастает.
Кроме исследования крови, пациентам должно проводиться обследование других органов и систем:
- При подозрении на заболевания мочевыделительной системы – УЗИ почек, общий анализ мочи, биохимический анализ крови с определением мочевины и креатинина.
- При подозрении на онкологический процесс план обследования назначается, исходя из локализации предположительного диагноза (от простат-специфического антигена или других онкомаркеров до компьютерной или магнитно-резонансной томографии соответствующего органа).
- Ревмопробы при подозрении на аутоиммунный процесс (определение С-реактивного белка, СОЭ, АСЛ-О, ревматоидного фактора и др) с последующей консультацией ревматолога.
- Пункция костного мозга при подозрении на апластический или миелодиспластический синдромы.
- Поиск причины кровотечения при геморрагическом патогенезе нормохромной анемии – фиброгастроскопия, исследования половой системы у женщин, колоноскопия, исследование печени.
Как лечить нормохромную анемию?
Терапия данного типа анемий всегда сводится к лечение основного заболевания. Тактика лечения при этом различается. При анемии хронического заболевания (АХЗ), обусловленной почечным, аутоиммунным или онкологическим механизмами, показано внутримышечное введение человеческого рекомбинантного эритропоэтина в дозировке 10000 МЕ трижды в неделю.

В том случае, если у пациента наблюдается сочетанный тип анемии, например, у пациентов с ревматоидным артритом (фолиево-дефицитная при приеме цитостатика метотрексата и нормохромная анемия хронического заболевания), показан и прием фолиевой кислоты, и препаратов, назначаемых ревматологом, способных уменьшить аутоиммунное воспаление в организме.
Вне зависимости от причинного фактора, в лечении и нормохромной анемии тоже используется прием железосодержащих препаратов, наряду с терапией основного заболевания. Это так называемые анемии с сочетанными патогенетическими механизмами. Также здесь может идти речь об анемии вследствие кровопотери (постгеморрагическая анемия).
- Анемия легкой степени тяжести (уровень гемоглобина от 90 до 120 г/л) лечится диетой с высоким содержанием железа (телятина, говяжья печень, гречка, гранаты), а также назначением таблетированных форм железа (феррум-лек, тотема, сорбифер дурулес) или растворов для внутримышечных инъекций (мальтофер).
- При анемии средней степени тяжести (уровень гемоглобина от 70 до 90 г/л) показано внутримышечное введение железосодержащих препаратов и эритропоэтина.
- При анемии тяжелой степени (уровень гемоглобина менее 70 г/л) показано переливание эритромассы (гемотрансфузия). Лечение при этом поддерживающее, так как эффекта от переливания хватает лишь на несколько месяцев.
Отдельно есть смысл остановиться на гемотрансфузии. Итак, основным показанием для переливания крови является прогрессирующее падении гемоглобина менее 70 г/л. Переливание эритромассы должно осуществляться только в стационаре под наблюдением врача-реаниматолога или профильного специалиста. Профиль отделения может варьировать – от хирургического или гинекологического стационара в случае массивных жизнеугрожающих внутренних кровотечений до онкологического или гематологического отделения при соответствующих злокачественных образованиях. Абсолютным противопоказанием для гемотрансфузии является острая сердечно-сосудистая недостаточность, сопровождаемая отеком легких, у терминальных (крайне тяжелых) пациентов в агональном состоянии.
Каковы осложнения и прогноз нормохромной анемии?
Осложнения анемии, как таковой, сводятся к гипоксии организма и наступлению летального исхода вследствие критического снижения гемоглобина в периферической крови (ниже 60 г/л и более). Но, как правило, смерть наступает не столько от самой анемии, сколько вследствие тяжелого причинного заболевания (осложнения гемодиализа, терминальная стадия онко-процесса, острое отравление гемолитическими ядами или летальная доза отравляющего вещества).
Таким образом, прогноз при нормохромной нормоцитарной анемии определяется основным заболеванием. Так, при своевременной коррекции острой или хронической кровопотери прогноз благоприятный, при хронических воспалительных или аутоиммунных заболеваниях прогноз для жизни благоприятный, а для здоровья – нет. При злокачественных опухолях или онко-гематологических заболеваниях прогноз неблагоприятный.
Читайте также:
